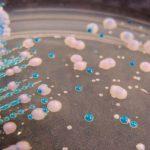
Infecciones recurrentes de levadura: cómo tratar la candidiasis vaginal que vuelve

Todas esas hormonas del embarazo le colocan en un riesgo más alto de infecciones de la levadura durante embarazo. ¿Son peligrosas las infecciones por hongos durante el embarazo, y qué remedios caseros y tratamientos médicos para la candidiasis vaginal durante el embarazo funcionan mejor?

Infecciones de levadura durante el embarazo: remedios caseros y tratamientos médicos para la candidiasis vaginal
La mayoría de las mujeres (tres de cada cuatro) experimentará una infección vaginal por levaduras, médicamente conocida como candidiasis vulvovaginal, al menos una vez durante sus vidas. Usted es más vulnerable a las infecciones de la levadura durante el embarazo, probablemente debido a sus mayores niveles de estrógeno y aumento de las cantidades de glucógeno, un azúcar, en la vagina. Como si toda esa enfermedad de la mañana, cansancio, estreñimiento, hinchazón, acidez y sentimiento general como una ballena no fuera suficiente, ¿verdad?
Los signos de una infección por levaduras incluyen:
- Picazón y sensaciones ardientes alrededor de la vagina y la vulva.
- Cambios en el flujo vaginal. Mientras que el flujo vaginal normal durante el embarazo es más probable que sea ligeramente acuoso, la secreción asociada con infecciones de levadura es blanca, gruesa y cremosa, más bien como un queso cottage.
- Es probable que su vagina y su vulva estén rojas y doloridas si tiene una infección por levaduras.
- Puede experimentar dolor o malestar durante las relaciones sexuales.
Si observa los síntomas de la infección por levaduras durante el embarazo, tendrá muchas preguntas: ¿Las infecciones por levaduras durante el embarazo representan un peligro para su bebé? ¿Qué tratamientos de infección por levaduras le ofrecerá a su OBGYN?
¿Quién es más probable para obtener una infección de levadura durante el embarazo?
El embarazo es en sí mismo un importante factor de riesgo para la candidiasis vulvovaginal: alrededor del 10 por ciento de todas las mujeres embarazadas tendrán un crecimiento excesivo de la levadura vaginal cuando estén a mitad de su embarazo. La mayoría de las infecciones por levaduras durante el embarazo son causadas por Candida albicans, pero otras especies, como Candida glabrata o Candida tropicalis, también pueden ser responsables de infecciones vaginales por levaduras durante el embarazo o en cualquier otro momento.
Es estadísticamente más probable que desarrolle una infección de levadura durante el embarazo si usted es:
- Negro
- Hispano
- Soltero
- Una usuaria anterior de los anticonceptivos hormonales.
- Ya una madre, y por lo tanto experimentando un embarazo posterior.
¿Son las infecciones de levadura durante el embarazo peligrosas para su bebé?
La investigación indica que las infecciones por hongos durante el embarazo no aumentan el riesgo de parto prematuro o un bebé de bajo peso al nacer. Los medicamentos antimicóticos y los corticosteroides tópicos utilizados para tratar las infecciones por levaduras durante el embarazo tampoco están asociados con defectos de nacimiento.
Sin embargo, es posible transmitir cualquier infección de levadura que tenga durante las últimas etapas de su embarazo a su bebé. Entre el 70 y el 85 por ciento de las mujeres que sufren de una infección de levadura vaginal durante el final de sus embarazos pasará esa infección de levadura en sus bebés.
Si bien esta transmisión puede causar nada más que el aftas oral inocuo en los bebés, la candidiasis invasiva (que puede ser letal) es una posibilidad, especialmente en los bebés que nacieron muy prematuramente, tienen muy bajo peso al nacer o son VIH positivos.
Tratamiento de infección de levadura durante el embarazo
Si se aproxima a su médico acerca de una sospecha de infección por levaduras durante el embarazo, el diagnóstico a menudo se hará simplemente mediante un examen físico. Sin embargo, dado que otras condiciones, como la vaginosis bacteriana, pueden presentarse con síntomas similares a los síntomas de una infección por levaduras, es posible que desee pedirle específicamente a su médico que tome un hisopo y lo envíe para pruebas de laboratorio.
ME GUSTA LO QUE VEO
Los medicamentos antimicóticos utilizados en el tratamiento de infecciones de levadura durante el embarazo incluyen:
- Imidazol, antifúngicos como butoconazol, clotrimazol y miconazol.
- Triazol, medicamentos antimicóticos como fluconazol y terconazol.
- Nistatina.
Estos medicamentos para el tratamiento de la infección por levaduras están disponibles por vía oral y como medicamentos tópicos, pero es importante tener en cuenta que los antifúngicos tópicos han sido estudiados en mujeres embarazadas y se consideran seguros, mientras que altas dosis de fluconazol oral han sido específicamente asociadas con defectos de nacimiento. Dosis más bajas todavía pueden ser consideradas en mujeres embarazadas cuyas infecciones por hongos no responden bien a otro tratamiento, y estas dosis menores no se han asociado con ningún resultado negativo del embarazo.
Tenga en cuenta que el tratamiento antifúngico tópico con azole debe utilizarse durante más tiempo para las infecciones de levadura durante el embarazo que para las infecciones por hongos que se producen durante otras épocas, durante siete días. Esto aumenta la probabilidad de que su infección de levadura se aclare.
Además de la medicación antifúngica, su médico puede recomendarle que use corticosteroides tópicos para aliviar la picazón vaginal y vulvar, y el dolor que puede estar experimentando como resultado de su infección por levaduras durante el embarazo. Discuta los riesgos y beneficios con su médico, pero sepa que los corticosteroides tópicos generalmente se consideran seguros para su uso en mujeres embarazadas.
Finalmente, si está cerca de su fecha de vencimiento o ya está en trabajo de parto, se le puede ofrecer profilaxis. Los recién nacidos que están especialmente en riesgo de invasiva, sistémica, candidiasis se dará el mismo.
¿Puedo terminar mi infección de la levadura en el hogar usando remedios naturales?
Varios remedios caseros para las infecciones vaginales de levadura han demostrado que funcionan bien en la lucha contra Candida albicans y otras especies de Candida. Sin embargo, debido a que las infecciones por levaduras durante el embarazo pueden transmitirse al bebé, ocasionalmente con resultados extremadamente indeseables, es importante siempre discutir el posible tratamiento domiciliario para infecciones vaginales por levaduras durante el embarazo con su médico, en lugar de hacerlo solo.
Un “tratamiento natural de la infección de la levadura” que es especialmente de nota es ácido bórico. Algunas preocupaciones se han planteado acerca de su seguridad durante el embarazo, con sugerencias de que el uso vaginal de ácido bórico durante puede conducir a defectos de nacimiento, sin embargo, los datos no fueron estadísticamente significativos. Esto significa que usted desea discutir las ventajas y los riesgos de usar el ácido bórico como tratamiento de la infección de la levadura muy cuidadosamente con su abastecedor de la asistencia sanitaria antes de ir a esta ruta, y usted deseará otros tratamientos para la infección de la levadura han demostrado ser eficaces. (Si desea tener una charla con su médico sobre el uso de ácido bórico para tratar una infección de levadura durante el embarazo, es posible que desee informarles que 600 mg se aplica por vía intravaginal durante dos semanas).
Una crema vaginal que contiene ajo, como el Vagina Pro ™ ajo crema de defensa vaginal, puede ser tan eficaz en el tratamiento de infecciones por hongos como cremas antifúngicas azole. Sin embargo, no inserte clavos de ajo crudos en la vagina, ya que esto puede causar irritación.
Usted puede usar probióticos Lactobacillus durante el embarazo para prevenir la aparición de infecciones por hongos. Mientras que los probióticos no se pueden considerar para ser una cura de la infección de la levadura por sí mismos, también se han demostrado para hacer el tratamiento antifúngico convencional para las infecciones vaginales más eficaces.
Otros tratamientos naturales de infección por levaduras que son prometedores son el aceite de orégano, el aceite de coco y el aceite del árbol del té.
Compartir Twittear +1 Compartir Pin StumbleUna vez más, asegúrese de ver a un médico si sospecha una infección por levaduras durante el embarazo. Si desea probar remedios alternativos para infecciones de levadura en lugar de usar antifúngicos convencionales por cualquier razón, siempre consulte a su médico y asegúrese de que está en la misma página. Esto es importante para mantener a su bebé a salvo.
¿HAS VISTO ESTOS ARTÍCULOS?
¿HAS VISTO ESTOS ARTÍCULOS?
-
 Diga no a la levadura: remedios caseros para el tratamiento y la prevención vaginal de la infección de levadura
Diga no a la levadura: remedios caseros para el tratamiento y la prevención vaginal de la infección de levaduraPor lo tanto, ¿se trata de una infección vaginal por levaduras (de nuevo)? Es posible…
-
Infecciones recurrentes de levadura: cómo tratar la candidiasis vaginal que vuelve
Infecciones recurrentes de levadura: cómo tratar la candidiasis vaginal que vuelve¿Sus infecciones vaginales de la levadura siguen volviendo? Los antifúngicos azólicos convencionales pueden no funcionar…
-
 Infecciones por levaduras en los bebés: ¿qué es lo que necesita saber sobre el tratamiento de la candidiasis bucal en los bebés?
Infecciones por levaduras en los bebés: ¿qué es lo que necesita saber sobre el tratamiento de la candidiasis bucal en los bebés?Hasta el siete por ciento de todos los bebés desarrollan una infección por levaduras conocida…
-
 La concepción y las infecciones por hongos
La concepción y las infecciones por hongosLas infecciones por hongos, candidiasis, candida o no importa como usted los llame, cada mujer…
-
 Dolor abdominal durante el embarazo: Causas y Tratamientos
Dolor abdominal durante el embarazo: Causas y TratamientosEs muy común que las mujeres embarazadas experimentar dolor abdominal, y la mayoría de la…
-
 Candidiasis vulvovaginal (Candidiasis Vaginal), la terapia
Candidiasis vulvovaginal (Candidiasis Vaginal), la terapiaMuchas sufren de candidiasis vulvovaginal o candidiasis vaginal. La infección recurrente es también común. La…

